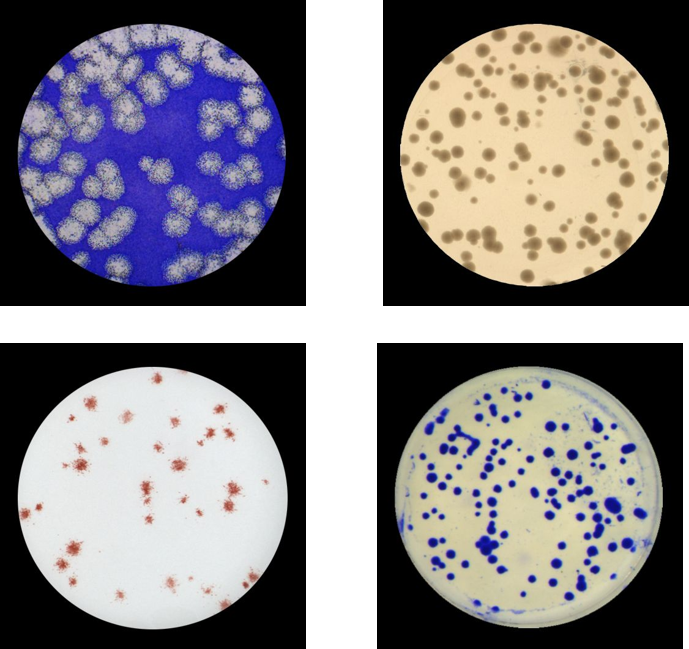

BioSnap™

コロニーカウント解析装置
BioSnap™ Telecentricの概要
BioSnap™ Telecentricは、ウイルスプラークアッセイやフォーカス形成アッセイ、コロニーカウントなど、様々なバイオアッセイを画像ベースで高精度かつ迅速に解析できる汎用システムです。自動プレートローダー ImmunoBot™(最大400プレートセット可能)と接続した自動化およびハイスループット解析にも柔軟に対応します。
アプリケーション
・ ウイルスプラーク解析(PRNT, 力価)・ フォーカス形成アッセイ(FFA)
・ バイオバーデン/微生物負荷/無菌試験
・ 抗生物質スクリーニング
・ 血清殺菌活性試験(SBA)
・オプソニン化貪食殺菌試験(OPKA)
・ 酵母コロニー形成/遺伝毒性試験
・ ウイルス細胞質内解析(ICA)
プレートフォーマット
・90 mmペトリディッシュ、6ウェル、12ウェル、24ウェル、48ウェル、(96ウェルプレート※)※96ウェルプレートは撮影のみ可能、スポット解析は非対応
標準ソフトウェア
・ImmunoSpot SCオプション
・ImmunoBot™ (最大400プレート対応ハイスループットプレートローダー)・バーコードリーダー
・Part11対応
本体仕様
| 本体サイズ | 56.0 cm (H)× 29.3 cm(W)× 34.1 cm (D) ※PCは含みません |
|---|---|
| 電源 | 120/230 V AC, 50/60 Hz |


